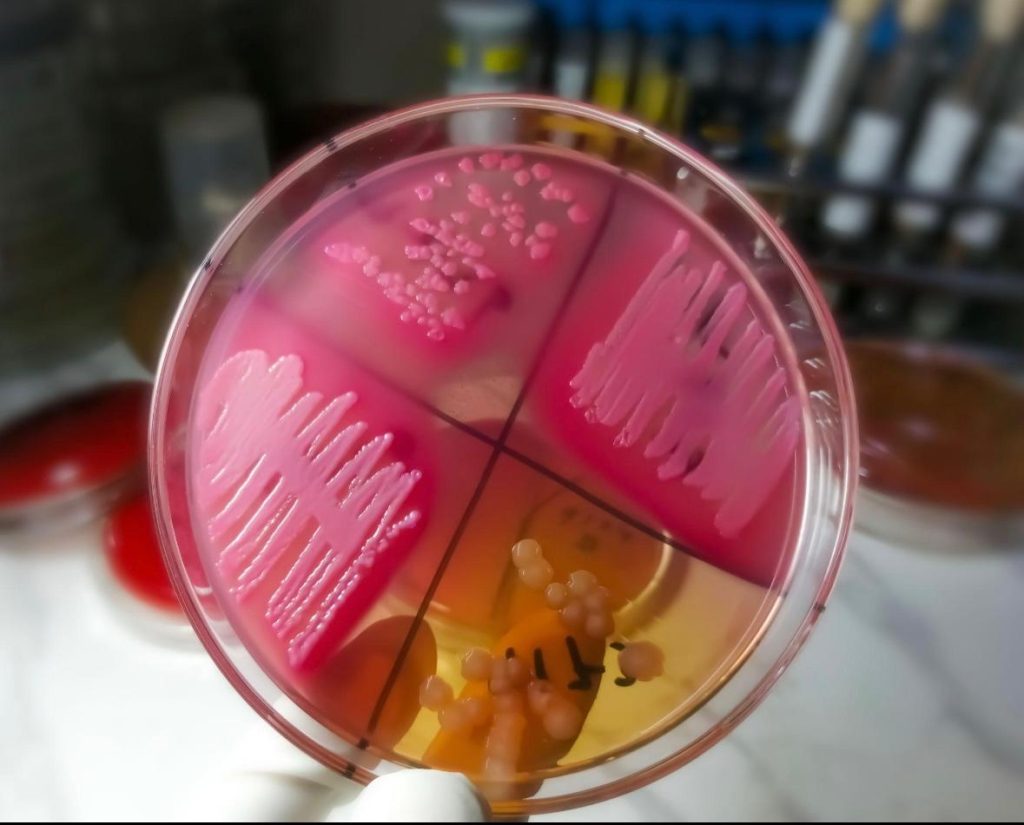

• Couples trying to conceive for more than 12 months without success
• Men who want to evaluate their fertility potential and sperm quality
• Men experiencing testicular problems, hormonal imbalance, or reproductive health issues
• Patients preparing for fertility treatments such as IUI, IVF, or ICSI
• Men who need confirmation of sperm presence or absence after vasectomy or reproductive surgery
- sakkthi@gmail.com
- Mon - Sun: 8.00 am - 7.00 pm
- Opp. G.H. Near Anusha Hospital, Erode - 09.